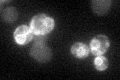
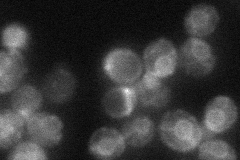
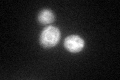
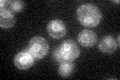

View description
Subunit of the GET complex; involved in insertion of proteins into the ER membrane; required for the retrieval of HDEL proteins from the Golgi to the ER in an ERD2 dependent fashion and for normal mitochondrial morphology and inheritance
Localization:
Intensity:
Fold change:
Significance:
-
C’ GFP library in SD
ER51.38 -
N' NOP1pr-GFP in SD

ER49.0814 -
N' TEF2pr-mCherry in SD

missing0 -
N' NATIVEpr-GFP in SD
ER45.542 -
N' TEF2pr-VC and Cyto-VN in SD

#N/A0 -
C’ GFP library in SD+DTT
ER42.070.81No -
C’ GFP library in SD+H2O2

ER39.690.77No -
C’ GFP library in Starvation Media
ER50.90.99No -
C’ GFP library on the background of Pup2-DaMP

ER -
C’ GFP library on the background of CCT mutant

ER51.69351.00592No
